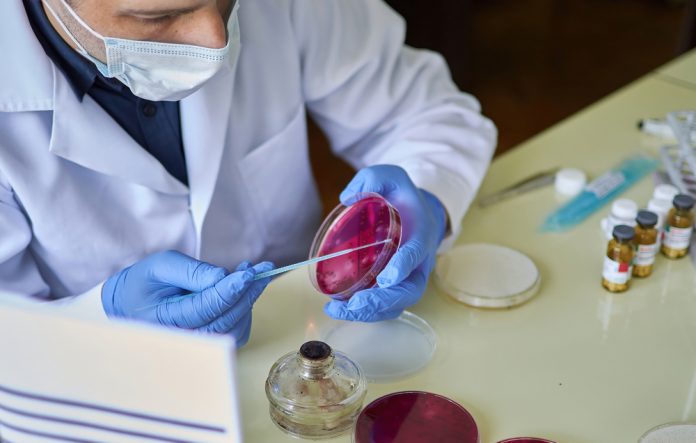

Dr. Thomas Inzana, professor and chief of research at the College of Veterinary Medicine, is ranked among the top 0.029% of researchers worldwide on the topic of Pasteurellaceae, a family of bacterial pathogens. Dr. Inzana has contributed to 15 scientific articles on the topic, and his research has earned millions in government funding and patents for vaccines.


